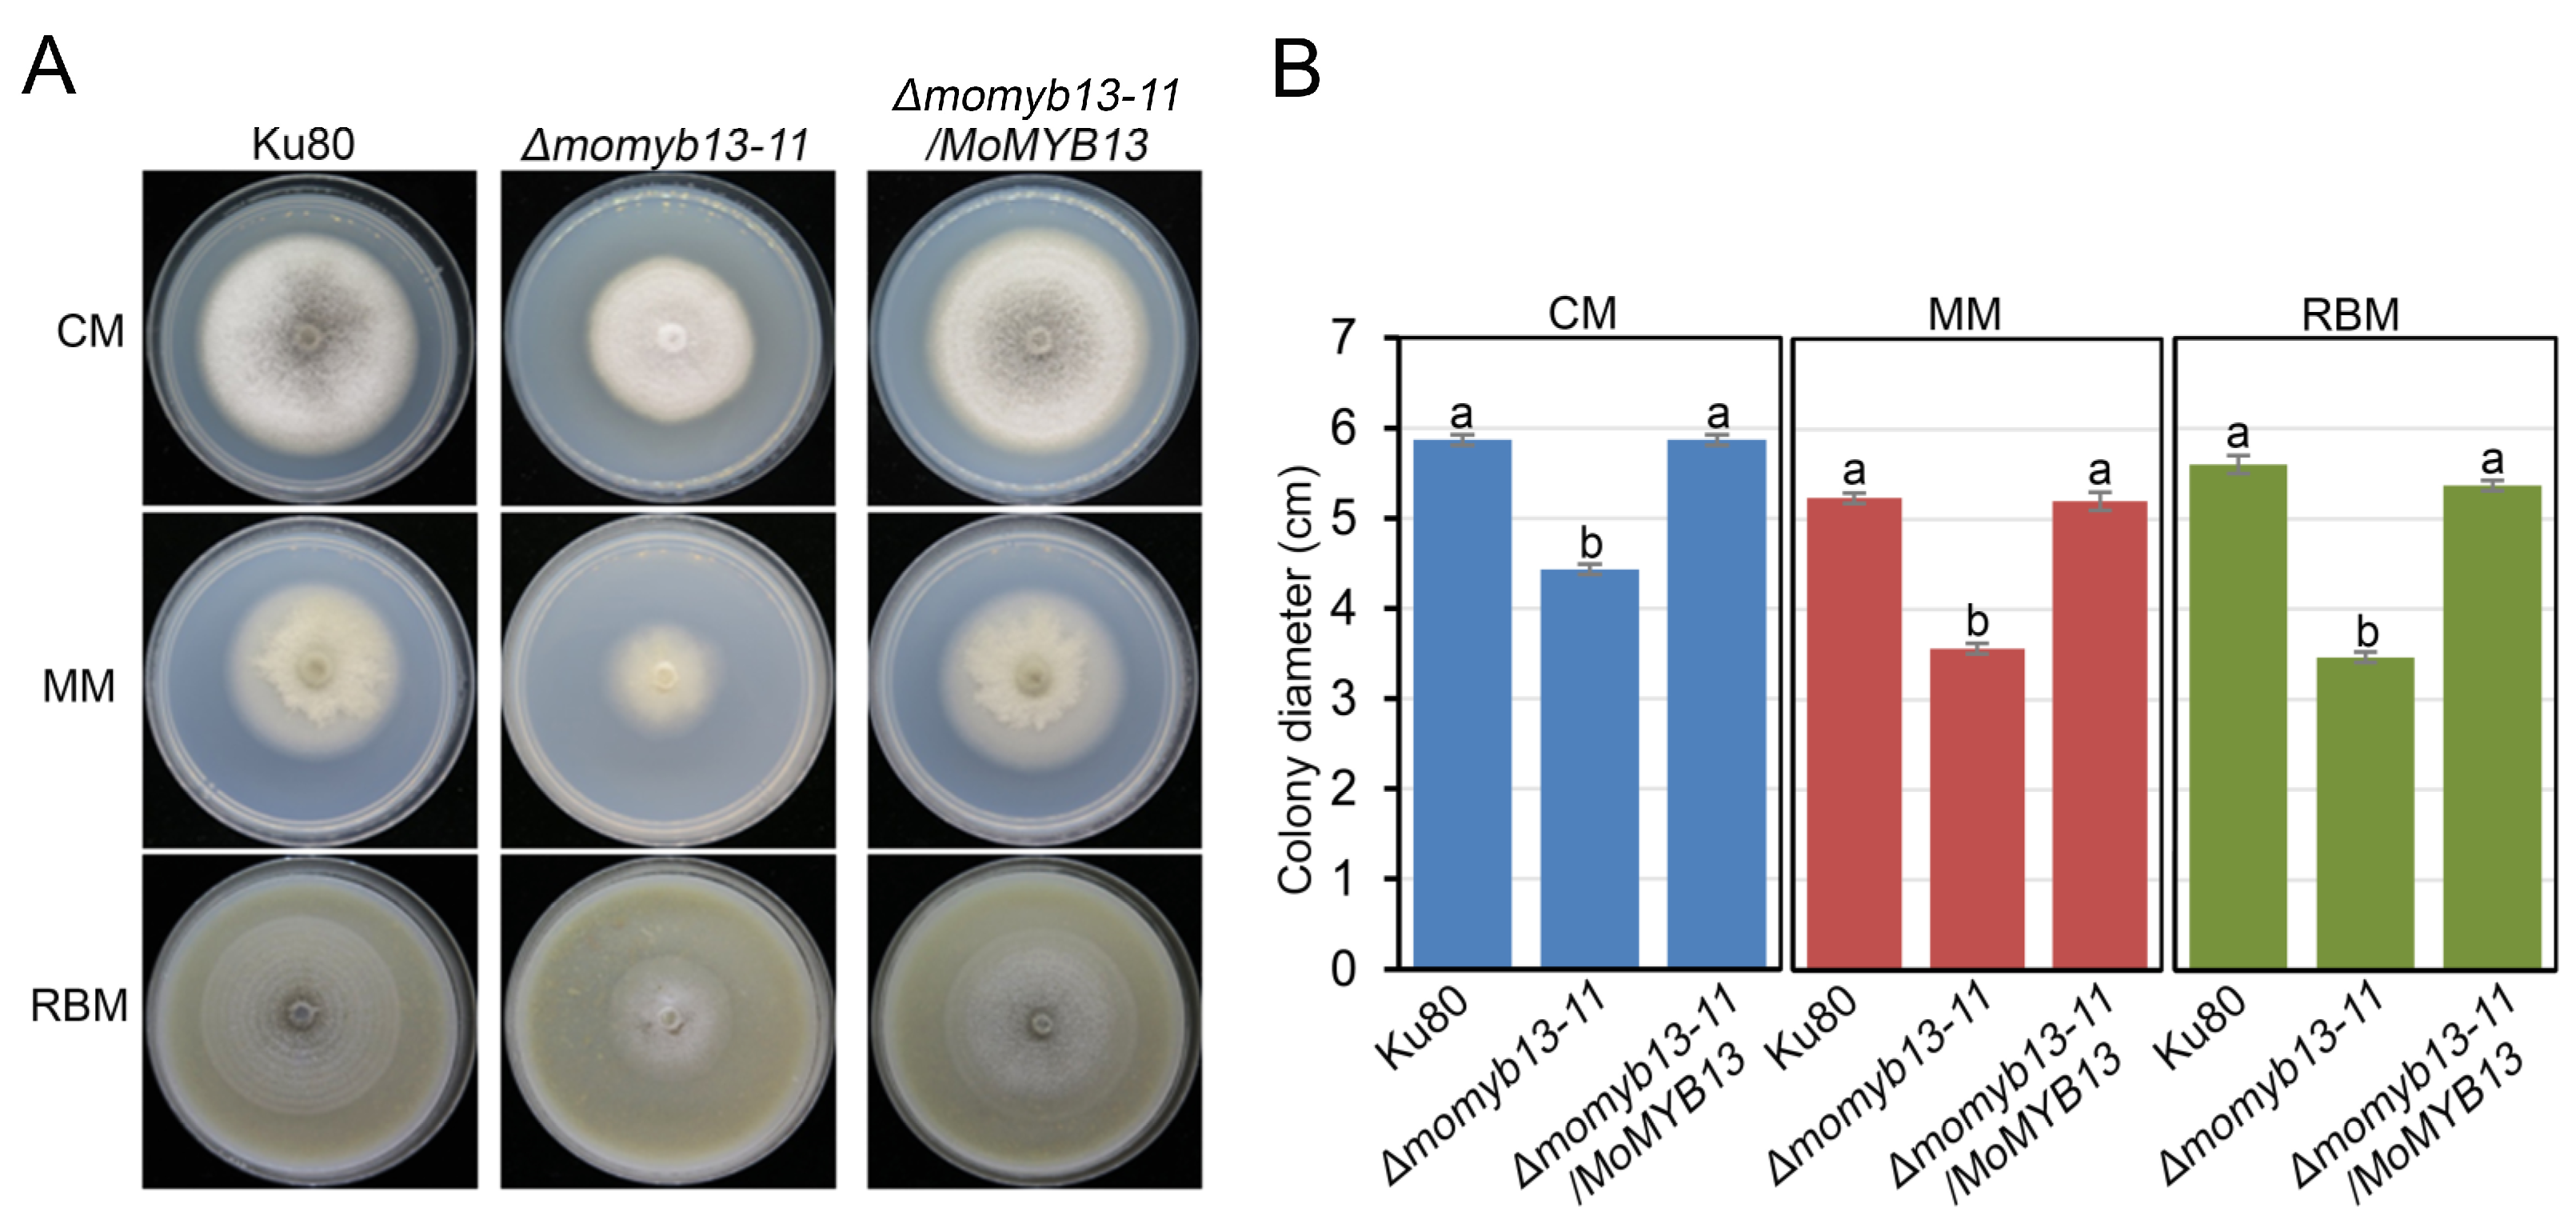
Agronomy 14 00251 g003

Functional Analysis of MoMyb13, a Myb Transcription Factor Involved in Regulating Growth, Conidiation, Hydrophobicity, and Pathogenicity of Magnaporthe oryzae
Abstract
1. Introduction
2. Materials and Methods
3. Results
3.1. Sequence Identification and Evolution Analysis of MoMyb13
3.2. Localization of MoMyb13 in the Nuclei of M. oryzae
3.3. MoMyb13 Is Required for the Growth of M. oryzae
3.4. MoMyb13 Is Essential for the Conidiogenesis of M. oryzae
3.5. MoMyb13 Is Essential for the Pathogenicity of M. oryzae
3.6. MoMyb13 Is Involved in Regulating Hydrophobins
3.7. MoMyb13 Is Involved in Stress Response
4. Discussion
5. Conclusions
Supplementary Materials
Author Contributions
Funding
Data Availability Statement
Acknowledgments
Conflicts of Interest
References
- Pennisi, E. Armed and Dangerous. Science 2010, 327, 804–805. [Google Scholar] [PubMed]
- Howard, R.J.; Ferrari, M.A.; Roach, D.H.; Money, N.P. Penetration of hard Substrates by a Fungus employing Enormous Turgor Pressures. Proc. Natl. Acad. Sci. USA 1991, 88, 11281–11284. [Google Scholar] [CrossRef] [PubMed]
- Kankanala, P.; Czymmek, K.; Valent, B. Roles for Rice Membrane Dynamics and Plasmodesmata during Biotrophic Invasion by the Blast Fungus. Plant Cell 2007, 19, 706–724. [Google Scholar] [CrossRef] [PubMed]
- Sakulkoo, W.; Osés-Ruiz, M.; Garcia, E.O.; Soanes, D.M.; Littlejohn, G.R.; Hacker, C.; Correia, A.; Valent, B.; Talbot, N.J. A Single Fungal MAP Kinase controls Plant Cell-to-cell invasion by The Rice Blast Fungus. Science 2018, 359, 1399–1403. [Google Scholar] [CrossRef] [PubMed]
- Gladieux, P.; Condon, B.; Ravel, S.; Soanes, D.; Maciel, J.L.N.; Nhani, A.; Chen, L.; Terauchi, R.; Lebrun, M.-H.; Tharreau, D.; et al. Gene Flow between Divergent Cereal- and Grass-Specific Lineages of the Rice Blast Fungus Magnaporthe oryzae. mBio 2018, 9, e01219-17. [Google Scholar] [CrossRef] [PubMed]
- Islam, M.T.; Croll, D.; Gladieux, P.; Soanes, D.M.; Persoons, A.; Bhattacharjee, P.; Hossain, S.; Gupta, D.R.; Rahman, M.; Mahboob, M.G.; et al. Emergence of Wheat Blast in Bangladesh was caused by a South American Lineage of Magnaporthe oryzae. BMC Biol. 2016, 14, 84. [Google Scholar] [CrossRef] [PubMed]
- Malaker, P.K.; Barma, N.C.D.; Tiwari, T.P.; Collis, W.J.; Duveiller, E.; Singh, P.K.; Joshi, A.K.; Singh, R.P.; Braun, H.-J.; Peterson, G.L.; et al. First Report of Wheat Blast Caused by Magnaporthe oryzae Pathotype triticum in Bangladesh. Plant Dis. 2016, 100, 2330. [Google Scholar] [CrossRef]
- Dean, R.A.; Talbot, N.J.; Ebbole, D.J.; Farman, M.L.; Mitchell, T.K.; Orbach, M.J.; Thon, M.; Kulkarni, R.; Xu, J.R.; Pan, H.; et al. The Genome Sequence of the Rice Blast Fungus Magnaporthe grisea. Nature 2005, 434, 980–986. [Google Scholar] [CrossRef]
- Ebbole, D.J. Magnaporthe as a Model for Understanding Host-Pathogen Interactions. Annu. Rev. Phytopathol. 2007, 45, 437–456. [Google Scholar] [CrossRef]
- Huang, P.Y.; Wang, J.; Li, Y.; Wang, Q.; Huang, Z.C.; Qian, H.; Liu, X.H.; Lin, F.C.; Lu, J.P. Transcription factors Vrf1 and Hox7 coordinately regulate appressorium maturation in the rice blast fungus Magnaporthe oryzae. Microbiol. Res. 2022, 263, 127141. [Google Scholar] [CrossRef]
- Verma, S.; Gazara, R.K.; Verma, P.K. Transcription Factor Repertoire of Necrotrophic Fungal Phytopathogen Ascochyta rabiei: Predominance of MYB Transcription Factors as Potential Regulators of Secretome. Front. Plant Sci. 2017, 8, 1037. [Google Scholar] [CrossRef]
- Park, S.-Y.; Choi, J.; Lim, S.-E.; Lee, G.-W.; Park, J.; Kim, Y.; Kong, S.; Kim, S.R.; Rho, H.-S.; Jeon, J.; et al. Global Expression Profiling of Transcription Factor Genes Provides New Insights into Pathogenicity and Stress Responses in the Rice Blast Fungus. PLoS Pathog. 2013, 9, e1003350. [Google Scholar] [CrossRef]
- Bhadauria, V.; Wang, L.-X.; Peng, Y.-L. Proteomic changes associated with deletion of the Magnaporthe oryzae conidial morphology-regulating gene COM1. Biol. Direct 2010, 5, 61. [Google Scholar] [CrossRef]
- Kim, S.; Park, S.-Y.; Kim, K.S.; Rho, H.-S.; Chi, M.-H.; Choi, J.; Park, J.; Kong, S.; Park, J.; Goh, J.; et al. Homeobox Transcription Factors Are Required for Conidiation and Appressorium Development in the Rice Blast Fungus Magnaporthe oryzae. PLoS Genet. 2009, 5, e1000757. [Google Scholar] [CrossRef]
- Matheis, S.; Yemelin, A.; Scheps, D.; Andresen, K.; Jacob, S.; Thines, E.; Foster, A.J. Functions of the Magnaporthe oryzae Flb3p and Flb4p transcription factors in the regulation of conidiation. Microbiol. Res. 2017, 196, 106–117. [Google Scholar] [CrossRef]
- Zhou, Z.; Li, G.; Lin, C.; He, C. Conidiophore Stalk-less1 Encodes a Putative Zinc-Finger Protein Involved in the Early Stage of Conidiation and Mycelial Infection in Magnaporthe oryzae. MPMI 2009, 22, 402–410. [Google Scholar] [CrossRef]
- Odenbach, D.; Breth, B.; Thines, E.; Weber, R.W.S.; Anke, H.; Foster, A.J. The transcription factor Con7p is a central regulator of infection-related morphogenesis in the rice blast fungus Magnaporthe Grisea. Mol. Microbiol. 2007, 64, 293–307. [Google Scholar] [CrossRef]
- Tang, W.; Ru, Y.; Hong, L.; Zhu, Q.; Zuo, R.; Guo, X.; Wang, J.; Zhang, H.; Zheng, X.; Wang, P.; et al. System-wide characterization of bZIP transcription factor proteins involved in infection-related morphogenesis of Magnaporthe Oryzae. Environ. Microbiol. 2015, 17, 1377–1396. [Google Scholar] [CrossRef]
- Mehrabi, R.; Ding, S.; Xu, J.-R. MADS-Box Transcription Factor Mig1 Is Required for Infectious Growth in Magnaporthe grisea. Eukaryot. Cell 2008, 7, 791–799. [Google Scholar] [CrossRef] [PubMed]
- Nishimura, M.; Fukada, J.; Moriwaki, A.; Fujikawa, T.; Ohashi, M.; Hibi, T.; Hayashi, N. Mstu1, an APSES Transcription Factor, Is Required for Appressorium-Mediated Infection in Magnaporthe grisea. Biosci. Biotechnol. Biochem. 2009, 73, 1779–1786. [Google Scholar] [CrossRef]
- Zhou, X.; Liu, W.; Wang, C.; Xu, Q.; Wang, Y.; Ding, S.; Xu, J. A MADS-box transcription factor MoMcm1 is required for male fertility, microconidium production and virulence in Magnaporthe oryzae. Mol. Microbiol. 2011, 80, 33–53. [Google Scholar] [CrossRef]
- Cao, Y.; Chen, J.; Xie, X.; Liu, S.; Jiang, Y.; Pei, M.; Wu, Q.; Qi, P.; Du, L.; Peng, B.; et al. Characterization of two infection-induced transcription factors of Magnaporthe oryzae reveals their roles in regulating early infection and effector expression. Mol. Plant Pathol. 2022, 23, 1200–1213. [Google Scholar] [CrossRef]
- Du, H.; Zhang, L.; Liu, L.; Tang, X.-F.; Yang, W.-J.; Wu, Y.-M.; Huang, Y.-B.; Tang, Y.-X. Biochemical and Molecular Characterization of Plant MYB Transcription Factor Family. Biochemistry 2009, 74, 1–11. [Google Scholar] [CrossRef]
- Prouse, M.B.; Campbell, M.M. The Interaction Between MYB Proteins and their Target DNA binding Sites. Biochim. Biophys. Acta (BBA)-Gene Regul. Mech. 2012, 1819, 67–77. [Google Scholar] [CrossRef]
- Roy, S. Function of MYB Domain Transcription Factors in Abiotic Stress and Epigenetic Control of Stress Response in Plant Genome. Plant Signal. Behav. 2016, 11, e1117723. [Google Scholar] [CrossRef]
- Wang, L.; Gao, W.; Wu, X.; Zhao, M.; Qu, J.; Huang, C.; Zhang, J. Genome-Wide Characterization and Expression Analyses of Pleurotus ostreatus MYB Transcription Factors during Developmental Stages and under Heat Stress Based on de novo Sequenced Genome. Int. J. Mol. Sci. 2018, 19, 2052. [Google Scholar] [CrossRef]
- Ambawat, S.; Sharma, P.; Yadav, N.R.; Yadav, R.C. MYB transcription factor genes as regulators for plant responses: An overview. Physiol. Mol. Biol. Plants 2013, 19, 307–321. [Google Scholar] [CrossRef]
- Eme, L.; Spang, A.; Lombard, J.; Stairs, C.W.; Ettema, T.J.G. Archaea and the Origin of Eukaryotes. Nat. Rev. Microbiol. 2017, 15, 711–723. [Google Scholar] [CrossRef]
- Allan, A.C.; Espley, R.V. MYBs Drive Novel Consumer Traits in Fruits and Vegetables. Trends Plant Sci. 2018, 23, 693–705. [Google Scholar] [CrossRef]
- Baldoni, E.; Genga, A.; Cominelli, E. Plant MYB Transcription Factors: Their Role in Drought Response Mechanisms. Int. J. Mol. Sci. 2015, 16, 15811–15851. [Google Scholar] [CrossRef]
- Cao, Y.; Li, K.; Li, Y.; Zhao, X.; Wang, L. MYB Transcription Factors as Regulators of Secondary Metabolism in Plants. Biology 2020, 9, 61. [Google Scholar] [CrossRef]
- Dubos, C.; Stracke, R.; Grotewold, E.; Weisshaar, B.; Martin, C.; Lepiniec, L. MYB Transcription Factors in Arabidopsis. Trends Plant Sci. 2010, 15, 573–581. [Google Scholar] [CrossRef]
- Li, J.; Han, G.; Sun, C.; Sui, N. Research Advances of MYB Transcription Factors in Plant Stress Resistance and Breeding. Plant Signal. Behav. 2019, 14, 1613131. [Google Scholar] [CrossRef]
- Liu, J.; Osbourn, A.; Ma, P. MYB Transcription Factors as Regulators of Phenylpropanoid Metabolism in Plants. Mol. Plant 2015, 8, 689–708. [Google Scholar] [CrossRef]
- Ma, D.; Constabel, C.P. MYB Repressors as Regulators of Phenylpropanoid Metabolism in Plants. Trends Plant Sci. 2019, 24, 275–289. [Google Scholar] [CrossRef]
- Yu, E.Y.; Yen, W.F.; Steinberg-Neifach, O.; Lue, N.F. Rap1 in Candida albicans: An Unusual Structural Organization and a Critical Function in Suppressing Telomere Recombination. Mol. Cell Biol. 2010, 30, 1254–1268. [Google Scholar] [CrossRef]
- Hogues, H.; Lavoie, H.; Sellam, A.; Mangos, M.; Roemer, T.; Purisima, E.; Nantel, A.; Whiteway, M. Transcription Factor Substitution during the Evolution of Fungal Ribosome Regulation. Mol. Cell 2008, 29, 552–562. [Google Scholar] [CrossRef]
- Rodríguez-Sánchez, L.; Rodríguez-López, M.; García, Z.; Tenorio-Gómez, M.; Schvartzman, J.B.; Krimer, D.B.; Hernández, P. The fission yeast rDNA-binding protein Reb1 regulates G1 phase under nutritional stress. J. Cell Sci. 2011, 124, 25–34. [Google Scholar] [CrossRef]
- Mukherjee, K.; Pandey, D.M.; Vidyarthi, A.S. Molecular Dynamics Simulation of Rap1 Myb-type domain in Saccharomyces cerevisiae. Bioinformation 2012, 8, 881–885. [Google Scholar] [CrossRef]
- Ramos-Sáenz, A.; González-Álvarez, D.; Rodríguez-Galán, O.; Rodríguez-Gil, A.; Gaspar, S.G.; Villalobo, E.; Dosil, M.; de la Cruz, J. Pol5 is an essential ribosome biogenesis factor required for 60S ribosomal subunit maturation in Saccharomyces cerevisiae. RNA 2019, 25, 1561–1575. [Google Scholar] [CrossRef]
- Valsecchi, I.; Sarikaya-Bayram, Ö.; Hoi, J.W.S.; Muszkieta, L.; Gibbons, J.; Prevost, M.; Mallet, A.; Krijnse-Locker, J.; Ibrahim-Granet, O.; Mouyna, I.; et al. MybA, a transcription factor involved in conidiation and conidial viability of the human pathogen Aspergillus fumigatus: A transcription factor regulating conidiation in Aspergillus. Mol. Microbiol. 2017, 105, 880–900. [Google Scholar] [CrossRef]
- Wieser, J.; Adams, T.H. flbD encodes a Myb-like DNA-binding protein that coordinates initiation of Aspergillus mdulans conidiophore development. Genes Dev. 1995, 9, 491–502. [Google Scholar] [CrossRef]
- Mateos, L.; Jiménez, A.; Revuelta, J.L.; Santos, M.A. Purine Biosynthesis, Riboflavin Production, and Trophic-Phase Span Are Controlled by a Myb-Related Transcription Factor in the Fungus Ashbya gossypii. Appl. Environ. Microbiol. 2006, 72, 5052–5060. [Google Scholar] [CrossRef]
- Mitra, P. Transcription Regulation of MYB: A Potential and Novel Therapeutic Target in Cancer. Ann. Transl. Med. 2018, 6, 443. [Google Scholar] [CrossRef]
- Pattabiraman, D.R.; Gonda, T.J. Role and Potential for Therapeutic targeting of MYB in Leukemia. Leukemia 2013, 27, 269–277. [Google Scholar] [CrossRef]
- Kim, Y.; Kim, H.; Son, H.; Choi, G.J.; Kim, J.C.; Lee, Y.W. MYT3, A Myb-Like Transcription Factor, Affects Fungal Development and Pathogenicity of Fusarium graminearum. PLoS ONE 2014, 9, e94359. [Google Scholar] [CrossRef]
- Lin, Y.; Son, H.; Lee, J.; Min, K.; Choi, G.J.; Kim, J.C.; Lee, Y.W. A Putative Transcription Factor MYT1 Is Required for Female Fertility in the Ascomycete Gibberella zeae. PLoS ONE 2011, 6, e25586. [Google Scholar] [CrossRef]
- Lin, Y.; Son, H.; Min, K.; Lee, J.; Choi, G.J.; Kim, J.C.; Lee, Y.W. A Putative Transcription Factor MYT2 Regulates Perithecium Size in the Ascomycete Gibberella zeae. PLoS ONE 2012, 7, e37859. [Google Scholar] [CrossRef]
- Dong, Y.; Zhao, Q.; Liu, X.; Zhang, X.; Qi, Z.; Zhang, H.; Zheng, X.; Zhang, Z. MoMyb1 is Required for Asexual Development and Tissue-specific Infection in the Rice Blast Fungus Magnaporthe oryzae. BMC Microbiol. 2015, 15, 37. [Google Scholar] [CrossRef]
- Lee, S.; Völz, R.; Song, H.; Harris, W.; Lee, Y.H. Characterization of the MYB Genes Reveals Insights into Their Evolutionary Conservation, Structural Diversity, and Functional Roles in Magnaporthe oryzae. Front. Microbiol. 2021, 12, 721530. [Google Scholar] [CrossRef]
- Villalba, F.; Collemare, J.; Landraud, P.; Lambou, K.; Brozek, V.; Cirer, B.; Morin, D.; Bruel, C.; Beffa, R.; Lebrun, M.-H. Improved gene targeting in Magnaporthe grisea by inactivation of MgKU80 required for non-homologous end joining. Fungal Genet. Biol. 2008, 45, 68–75. [Google Scholar] [CrossRef]
- Li, Y.; Que, Y.; Liu, Y.; Yue, X.; Meng, X.; Zhang, Z.; Wang, Z. The Putative Gγ Subunit Gene MGG1 is required for Conidiation, Appressorium Formation, mating and Pathogenicity in Magnaporthe oryzae. Curr. Genet. 2015, 61, 641–651. [Google Scholar] [CrossRef]
- Li, Y.; Yue, X.; Que, Y.; Yan, X.; Ma, Z.; Talbot, N.J.; Wang, Z. Characterisation of Four LIM Protein-Encoding Genes Involved in Infection-Related Development and Pathogenicity by the Rice Blast Fungus Magnaporthe oryzae. PLoS ONE 2014, 9, e88246. [Google Scholar] [CrossRef]
- Li, Y.; Yan, X.; Wang, H.; Liang, S.; Ma, W.-B.; Fang, M.-Y.; Talbot, N.J.; Wang, Z.-Y. MoRic8 Is a Novel Component of G-Protein Signaling During Plant Infection by the Rice Blast Fungus Magnaporthe oryzae. Mol. Plant-Microbe Interact. 2010, 23, 317–331. [Google Scholar] [CrossRef]
- Li, Y.; Zheng, X.; Zhu, M.; Chen, M.; Zhang, S.; He, F.; Chen, X.; Lv, J.; Pei, M.; Zhang, Y.; et al. MoIVD-Mediated Leucine Catabolism Is Required for Vegetative Growth, Conidiation and Full Virulence of the Rice Blast Fungus Magnaporthe oryzae. Front. Microbiol. 2019, 10, 444. [Google Scholar] [CrossRef]
- Li, Y.; Zhu, J.; Hu, J.; Meng, X.; Zhang, Q.; Zhu, K.; Chen, X.; Chen, X.; Li, G.; Wang, Z.; et al. Functional characterization of electron-transferring flavoprotein and its dehydrogenase required for fungal development and plant infection by the rice blast fungus. Sci. Rep. 2016, 6, 24911. [Google Scholar] [CrossRef]
- Li, Y.; Liang, S.; Yan, X.; Wang, H.; Li, D.; Soanes, D.M.; Talbot, N.J.; Wang, Z.; Wang, Z. Characterization of MoLDB1 Required for Vegetative Growth, Infection-Related Morphogenesis, and Pathogenicity in the Rice Blast Fungus Magnaporthe oryzae. Mol. Plant-Microbe Interact. 2010, 23, 1260–1274. [Google Scholar] [CrossRef]
- Talbot, N.J.; Kershaw, M.J.; Wakley, G.E.; De Vries, O.; Wessels, J.; Hamer, J.E. MPG1 Encodes a Fungal Hydrophobin Involved in Surface Interactions during Infection-Related Development of Magnaporthe grisea. Plant Cell 1996, 8, 985–999. [Google Scholar] [CrossRef]
- Livak, K.J.; Schmittgen, T.D. Analysis of Relative Gene Expression Data Using Real-Time Quantitative PCR and the 2−ΔΔCT Method. Methods 2001, 25, 402–408. [Google Scholar] [CrossRef]
- Zhu, S.; Yan, Y.; Qu, Y.; Wang, J.; Feng, X.; Liu, X.; Lin, F.; Lu, J. Role refinement of melanin synthesis genes by gene knockout reveals their functional diversity in Pyricularia oryzae strains. Microbiol. Res. 2021, 242, 126620. [Google Scholar] [CrossRef]
- Berger, B.W.; Sallada, N.D. Hydrophobins: Multifunctional Biosurfactants for Interface Engineering. J. Biol. Eng. 2019, 13, 10. [Google Scholar] [CrossRef]
- Bayry, J.; Aimanianda, V.; Guijarro, J.I.; Sunde, M.; Latgé, J.P. Hydrophobins—Unique Fungal Proteins. PLoS Pathog. 2012, 8, e1002700. [Google Scholar] [CrossRef]
- Beckerman, J.L. MPG1, a Gene Encoding a Fungal Hydrophobin of Magnaporthe grisea, Is Involved in Surface Recognition. Mol. Plant-Microbe Interact. 1996, 9, 450. [Google Scholar] [CrossRef]
- Mavridi-Printezi, A.; Menichetti, A.; Mordini, D.; Amorati, R.; Montalti, M. Recent Applications of Melanin-like Nanoparticles as Antioxidant Agents. Antioxidants 2023, 12, 863. [Google Scholar] [CrossRef]
- Chumley, F.G.; Valent, B. Genetic-analysis of melanin-deficient, nonpathogenic mutants of Magnaporthe grisea. Mol. Plant-Microbe Interact. 1990, 3, 135–143. [Google Scholar] [CrossRef]
- Kou, Y.; Qiu, J.; Tao, Z. Every Coin Has Two Sides: Reactive Oxygen Species during Rice–Magnaporthe oryzae Interaction. Int. J. Mol. Sci. 2019, 20, 1191. [Google Scholar] [CrossRef]
- Collado, J.; Gonzalez, A.; Platas, G.; Stchigel, A.M.; Guarro, J.; Pelaez, F. Monosporascus ibericus sp. nov., an Endophytic Ascomycete from Plants on Saline Soils, with Observations on the Position of the Genus based on Sequence Analysis of the 18S rDNA. Mycol. Res. 2002, 106, 118–127. [Google Scholar] [CrossRef]
- Liu, K.; Ding, X.; Deng, B.; Chen, W. Isolation and Characterization of Endophytic Taxol-producing Fungi from Taxus chinensis. J. Ind. Microbiol. Biotechnol. 2009, 36, 1171–1177. [Google Scholar] [CrossRef]
- Al-Khawaldeh, M.M.; Araj, S.-E.; Alananbeh, K.M.; Antary, T.M.A. Wheat Cultivable Fungal Endophytes in Jordan. Fresenius Environ. Bull. 2020, 29, 13. [Google Scholar]
- Geisen, S.; Hooven, F.C.; Kostenko, O.; Snoek, L.B.; Putten, W.H. Fungal Root Endophytes Influence Plants in a Species-specific Manner that depends on Plant’s Growth Stage. J. Ecol. 2021, 109, 1618–1632. [Google Scholar] [CrossRef]
- Sarsaiya, S.; Jain, A.; Fan, X.; Jia, Q.; Xu, Q.; Shu, F.; Zhou, Q.; Shi, J.; Chen, J. New Insights into Detection of a Dendrobine Compound from a Novel Endophytic Trichoderma longibrachiatum Strain and Its Toxicity Against Phytopathogenic Bacteria. Front. Microbiol. 2020, 11, 337. [Google Scholar] [CrossRef] [PubMed]
- Gao, H.; Pan, M.; Tian, C.; Fan, X. Cytospora and Diaporthe Species Associated with Hazelnut Canker and Dieback in Beijing, China. Front. Cell. Infect. Microbiol. 2021, 11, 664366. [Google Scholar] [CrossRef] [PubMed]
- Chen, H.; Mao, L.; Zhao, N.; Xia, C.; Liu, J.; Kubicek, C.P.; Wu, W.; Xu, S.; Zhang, C. Verification of TRI3 Acetylation of Trichodermol to Trichodermin in the Plant Endophyte Trichoderma taxi. Front. Microbiol. 2021, 12, 731425. [Google Scholar] [CrossRef] [PubMed]
- Zhdanova, N.; Fomina, M.; Redchitz, T.; Olsson, S. Chernobyl effect: Growth Characteristics of Soil Fungi Cladosporium cladosporioisdes (Fresen) De Vries with and without Positive Radiotropism. Pol. J. Ecol. 2001, 49, 309–318. [Google Scholar]
- Dadachova, E.; Casadevall Arturo, A. Ionizing radiation: How fungi cope, adapt, and exploit with the help of melanin. Curr. Opin. Microbiol. 2008, 11, 525–531. [Google Scholar] [CrossRef]
- Tornberg, K.; Olsson, S. Detection of hydroxyl radicals produced by wood-decomposing fungi. FEMS Microbiol. Ecol. 2002, 40, 13–20. [Google Scholar] [CrossRef][Green Version]
- Sivasubramanian, R. Redefining Plant-Necrotroph Interactions: The Thin Line Between Hemibiotrophs and Necrotrophs. Front. Microbiol. 2021, 12, 673518. [Google Scholar] [CrossRef]

Disclaimer/Publisher’s Note: The statements, opinions and data contained in all publications are solely those of the individual author(s) and contributor(s) and not of MDPI and/or the editor(s). MDPI and/or the editor(s) disclaim responsibility for any injury to people or property resulting from any ideas, methods, instructions or products referred to in the content. |
© 2024 by the authors. Licensee MDPI, Basel, Switzerland. This article is an open access article distributed under the terms and conditions of the Creative Commons Attribution (CC BY) license (https://creativecommons.org/licenses/by/4.0/).
Share and Cite
Li, Y.; Zheng, X.; Pei, M.; Chen, M.; Zhang, S.; Liang, C.; Gao, L.; Huang, P.; Olsson, S. Functional Analysis of MoMyb13, a Myb Transcription Factor Involved in Regulating Growth, Conidiation, Hydrophobicity, and Pathogenicity of Magnaporthe oryzae. Agronomy 2024, 14, 251. https://doi.org/10.3390/agronomy14020251
Li Y, Zheng X, Pei M, Chen M, Zhang S, Liang C, Gao L, Huang P, Olsson S. Functional Analysis of MoMyb13, a Myb Transcription Factor Involved in Regulating Growth, Conidiation, Hydrophobicity, and Pathogenicity of Magnaporthe oryzae. Agronomy. 2024; 14(2):251. https://doi.org/10.3390/agronomy14020251
Chicago/Turabian StyleLi, Ya, Xiuxia Zheng, Mengtian Pei, Mengting Chen, Shengnan Zhang, Chenyu Liang, Luyao Gao, Pin Huang, and Stefan Olsson. 2024. "Functional Analysis of MoMyb13, a Myb Transcription Factor Involved in Regulating Growth, Conidiation, Hydrophobicity, and Pathogenicity of Magnaporthe oryzae" Agronomy 14, no. 2: 251. https://doi.org/10.3390/agronomy14020251
APA StyleLi, Y., Zheng, X., Pei, M., Chen, M., Zhang, S., Liang, C., Gao, L., Huang, P., & Olsson, S. (2024). Functional Analysis of MoMyb13, a Myb Transcription Factor Involved in Regulating Growth, Conidiation, Hydrophobicity, and Pathogenicity of Magnaporthe oryzae. Agronomy, 14(2), 251. https://doi.org/10.3390/agronomy14020251

